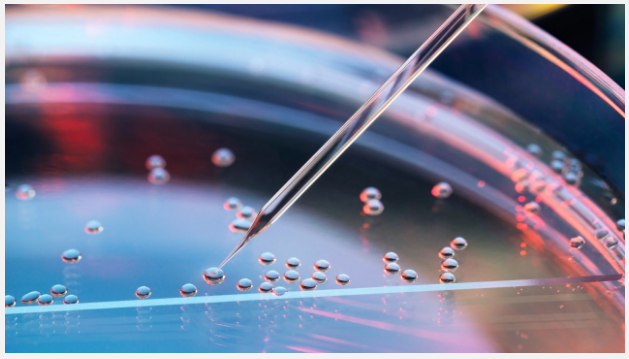

Kök hücreden insan embriyosu üretildi!
Bilim insanları, insan embriyo gelişiminin ilk aşamasını yeniden oluşturmak için kök hücre kullandı. Araştırmacılar, çalışmayı üreme tedavileri için dönüm noktası niteliğinde keşif olarak tanımladı.
Exeter Üniversitesi ve Cambridge Üniversitesinden araştırmacılar yaptıkları çalışmayı, Cell Stem Cell dergisinde yayımladılar.
Araştırmada, bir dizi hücre tipine dönüşebilen kök hücrelerin insan embriyolarının erken yapısını taklit ettiği bir yöntem geliştirdiler. Ekip, keşfin kısırlık tedavisinde temel anlayışları ve düşüğü önlemede koşulları iyileştireceğini söyledi.
Anahtar Kelime: kök hücreden insan embriyosu
